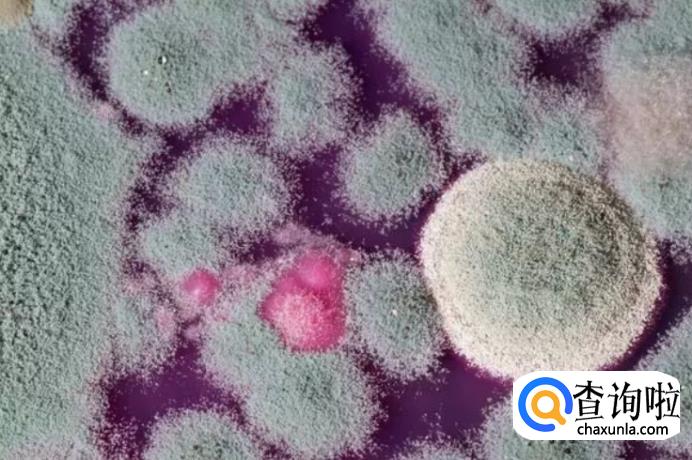

简要回答
女性阴道炎有哪些症状呢?一起来看看吧!

详细内容
- 01
临床上会表现为阴道分泌物呈现豆腐渣一样,并且伴有外阴瘙痒以及外阴红肿,而且有人还会出现尿频、尿急。

- 02
常常表现为阴道分泌物呈黄色泡沫样,并且伴有外阴瘙痒,白带稀薄脓性,黄绿色,有臭味,呈泡沫状,是由阴道滴虫感染引起的阴道炎症。主要经性交直接传播,也有经公共浴池,浴盆,浴巾,游泳池,坐便衣物污染的器械及敷料等传播。

- 03
症状:白带增多,灰白色,稀薄,呈泡沫状。阴道黏膜充血,散见出血点,外阴瘙痒并有灼痛感,阴部恶臭。
危害:诱发生殖器感染,盆腔炎、肾周炎、性交痛等。 - 04
这种阴道炎症常常表现为阴道分泌物增多,并且有外阴瘙痒,而且有人会出现尿频、尿急的情况。

- 05
典型症状
临床症状主要为外阴疼痛、痒感、分泌物增多。外阴、阴蒂、尿道口及阴道口黏膜充血、水肿、并有脓
性分泌物。局部有抓痕、出血等现象。
其他症状
严重者小阴唇粘连,尿流变细。
- 06
症状:白带增多,色黄,呈水状,严重时呈脓性,有臭味,有时可有血性或伴点滴出血,外阴有瘙痒或灼热感,下腹部坠胀,波及尿道时,有尿频、尿急、尿痛等。
危害:引发阴道粘连,阴道积脓或宫腔积脓。
- 07
症状:阴道有下坠感、灼热,伴有盆腔不适及全身乏力。阴道分泌物增多,呈脓性、浆液性,有臭味。由于分泌物刺激尿道口,可引起尿频、尿急、尿痛。
危害:引发阴道粘连、阴道积脓或宫腔积脓,易引起盆腔炎、胎膜早破和绒膜羊膜炎等。
- 08
症状:外阴瘙痒,外阴及阴道灼痛,白带增多呈豆腐渣样,有时伴有尿频、尿频、尿痛,性交痛。妇科检查时可见小阴唇内侧及阴道粘膜上附着白色膜状物,擦除后露出红肿粘膜面,急性期可见受损的糜烂面或表浅溃疡。
危害:不易根治,易反复,引发早产、胎儿感染畸形等。
- 09
过度清洁
频繁地使用药物清洁剂或者洗剂来清洗外阴也是导致阴道炎的原因。要知道,物极必反,每天用清水清洗外阴便已经足够,千万不要多此一举地选择肥皂和洗剂。
另外需要注意的是,频繁地使用卫生护垫,你以为身体干净了,其实正相反,它所形成的紧闭的环境容易破坏阴道固有的微环境,降低了阴道的自我抗菌能力。
因此,与其每天费力地用各种方法清洗,不如一次购买一打全棉内裤,天天换洗,每3个月更换一次。 - 010
乱用抗生素
广谱类抗生素在杀灭致病菌的同时,也抑制了部分有益菌群,而未被抑制的和外来耐药菌就会乘机大量繁殖,这其中就包括霉菌。这样一来,我们就极易患“念珠菌阴道炎”。因此,要切记抗生素使用需慎之又慎。 - 011
塑身塑出问题来
很多人为了拥有迷人的身材,都会想尽各种办法塑身、瘦身,其中不乏喜好使用塑身内衣的人。在购买紧身内衣的时候,千万不可贪图便宜购买了化纤类紧身内裤,因为它可以使阴道局部的温度以及湿度增高,又闷又热的环境可是滋养霉菌的安乐窝! - 012
使用洗衣机不消毒
事实上,几乎每台洗衣机内都暗藏霉菌!并且,卫生调查显示,衣服上的大量霉菌也大部分来自于洗衣机,洗得越勤,霉菌越多。因此,千万要记住定时用60摄氏度以上的热水浸泡洗衣机桶,霉菌惧怕高温,60摄氏度以上的高温会令它们立即消失无踪。 - 013
内裤、袜子一起洗
寄生在各个地方的细菌很容易互相传染,倘若你患有脚癣,却又把内衣裤同袜子放到一块儿清洗,那么这些“串门子”的霉菌可就变成了引发阴道炎并反复感染的罪魁祸首。所以,内衣裤一定要单独清洗哦。 - 014
无条件使用避孕药
有些女性在服用避孕药后容易引发霉菌性阴道炎,因为避孕药中的雌激素有促进霉菌生成菌丝的作用,导致它进一步侵袭阴道组织。这时候,如果还坚持服用避孕药就是你的错了,你应该立即改用其他避孕方法,这不仅保障了你,也保障了他的身体健康。
点击排行
- 2 排行
- 3 排行
- 4 排行
- 5 排行
- 6 排行
- 7 排行
- 8 排行
- 9 排行
- 10 排行





















